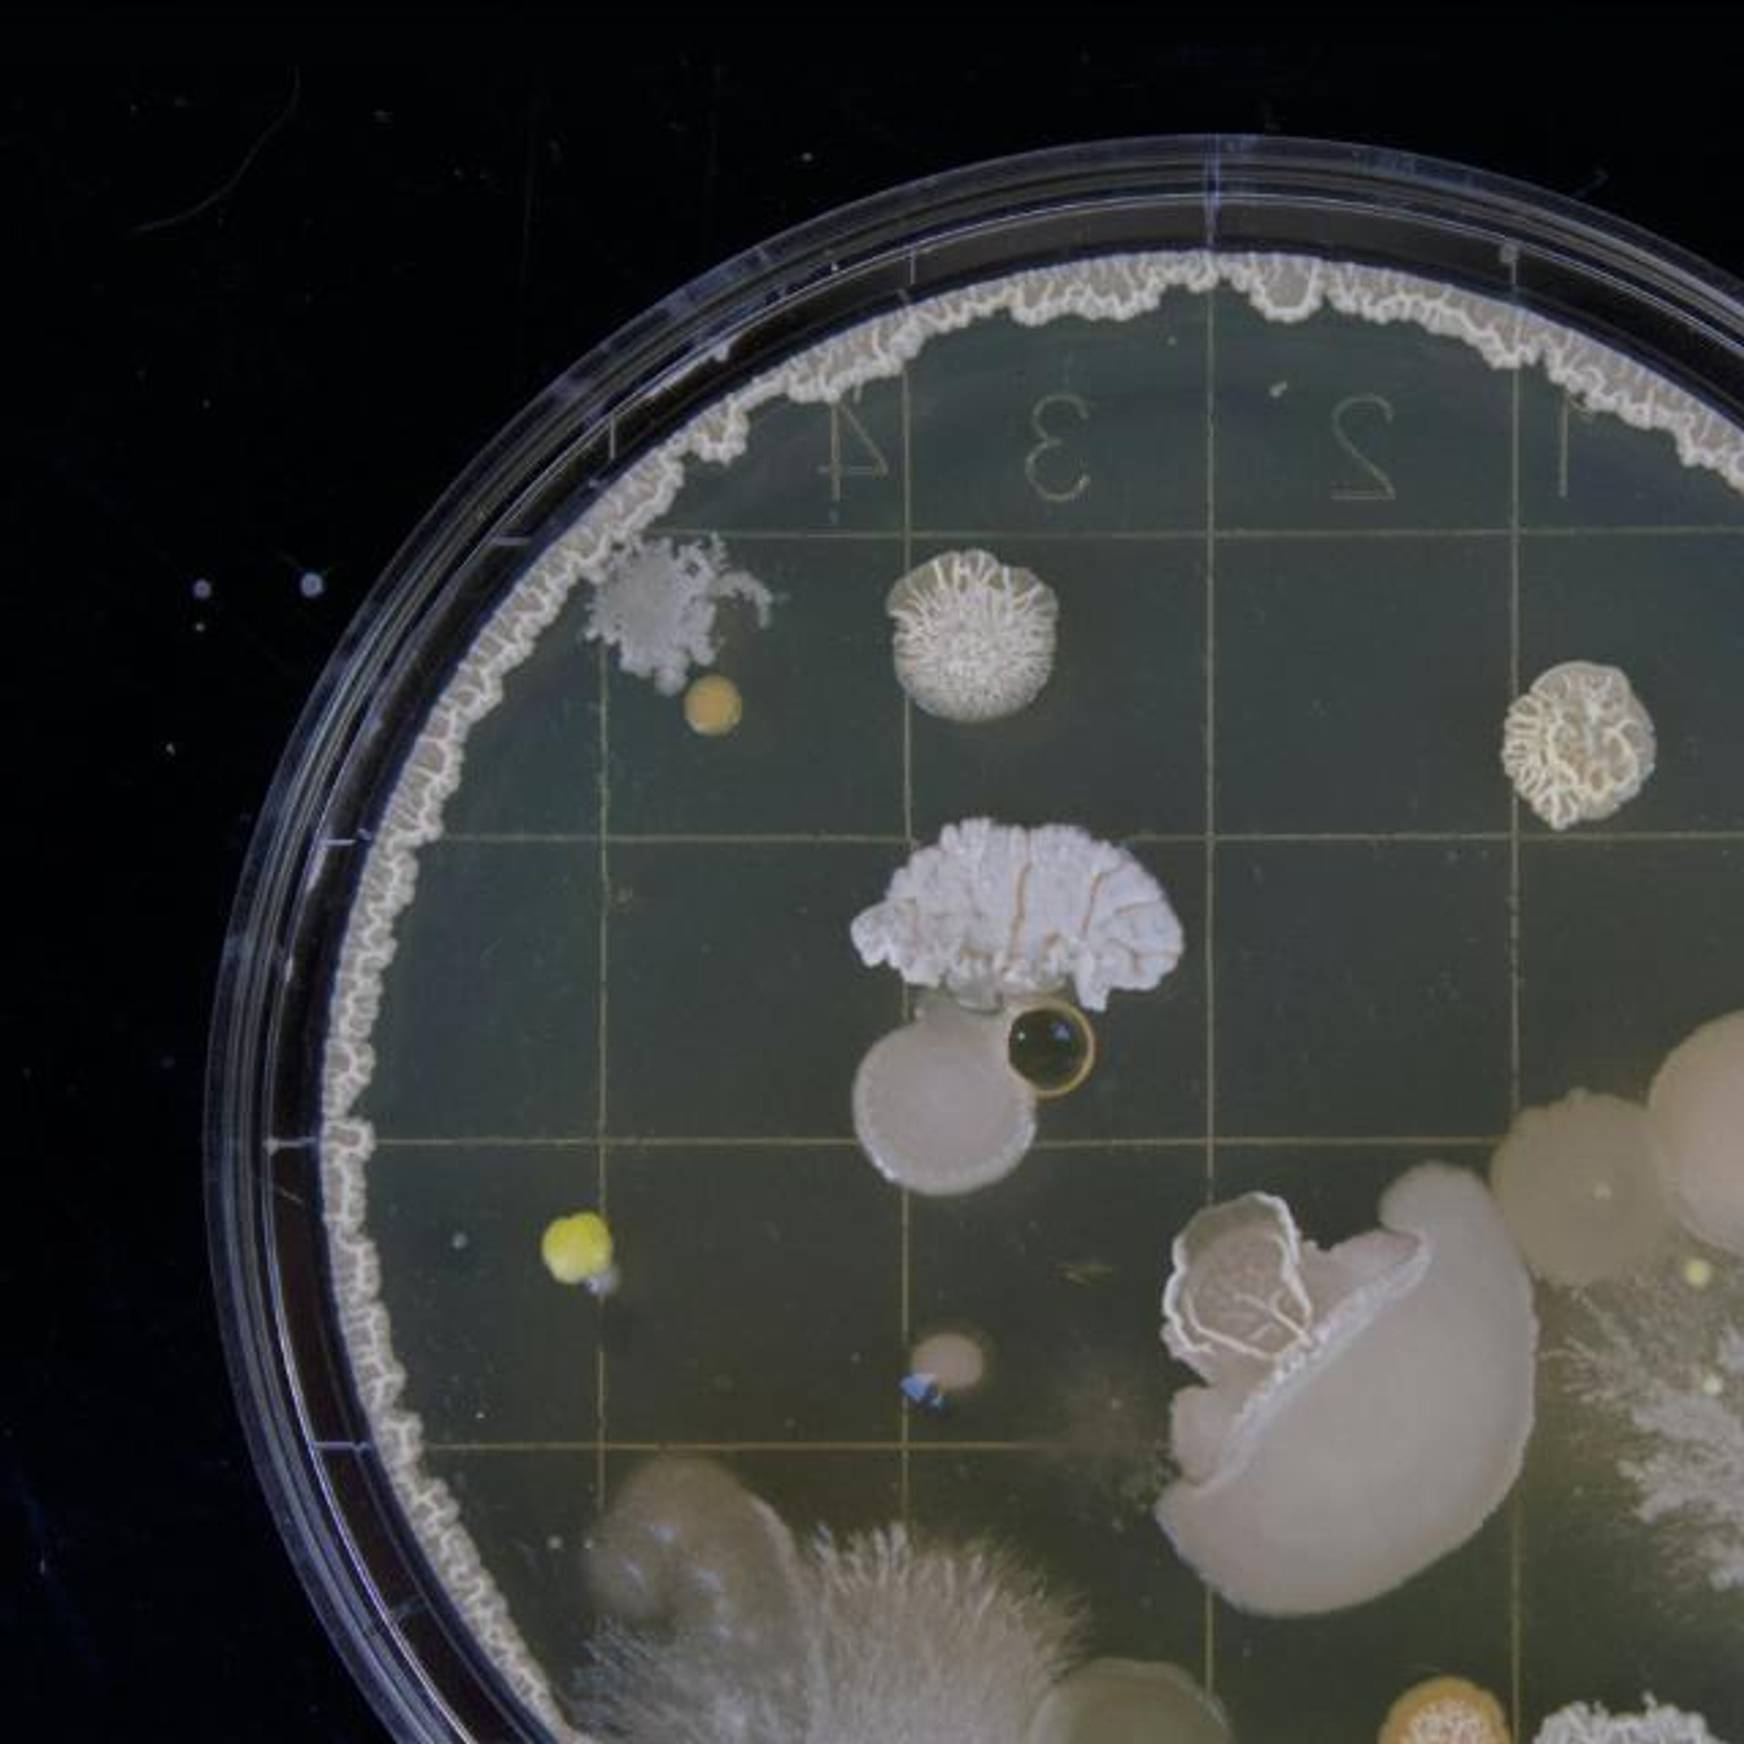
Bacteria sample

BE SUFFOLK
澳洲幸运10开奖官网开奖记录结果 Our Latest News
澳洲幸运10开奖官网开奖记录结果 Our Latest News
-
 Community, Research
Community, Research
Research recommends ‘one front door’ approach to support victim-survivors of sexual violence in Suffolk
A single point of referral is among a series of recommendations to better support sexual violence victims in the county, following a new study by researchers at the University of Suffolk. -
-may-2024-strategiq.jpg) Community, Health, Research
Community, Health, Research
University involved in new £4.5m project to improve healthcare in rural and coastal areas
The University of Suffolk will play a key role in a new £4.5 million research project which aims to improve healthcare in disadvantaged urban communities and rural and coastal areas of England. -
 Community, Student Achievement, Academic Achievement
Community, Student Achievement, Academic Achievement
澳洲幸运10开奖官网开奖记录结果 University Celebrates First Ever PhD in Creative Writing
A mature student who started his course at the University of Suffolk during the Covid 19 pandemic is celebrating becoming the institution’s first student to complete a PhD in Creative Writing. -
 Community, Student Achievement
Community, Student Achievement
澳洲幸运10开奖官方网站 澳洲行运10查询历史记录 Large new artwork on Ipswich Waterfront designed by Suffolk graduate
A huge new public artwork has been unveiled on Ipswich’s iconic Paul’s silo building, inspired by the award-winning design of University of Suffolk graduate Sammi Wong.
.jpg)
WHY SUFFOLK
2nd in the UK for Career Prospects
WUSCA 20243rd in the UK for spend on academic services
Complete University Guide 20254th in the UK for Teaching Satisfaction
Guardian University Guide 2024.jpg)





-640x640.jpg)

-640x640.jpg)